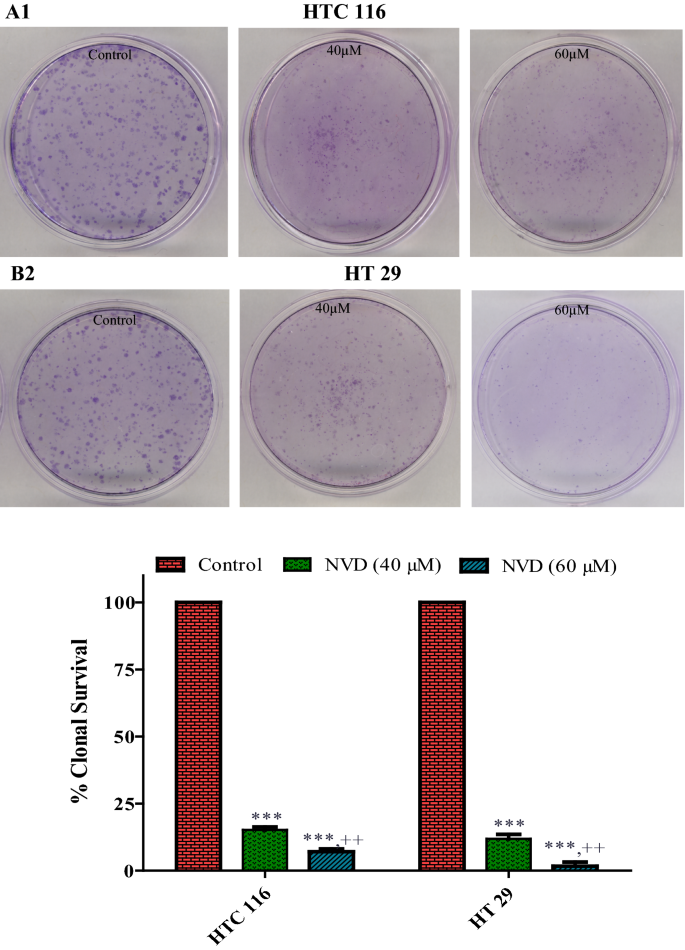
NVD对结直肠癌细胞克隆形成能力的影响

1. 领域背景与文献引入
文献英文标题:RETRACTED ARTICLE: Growth inhibition and apoptosis in colorectal cancer cells induced by Vitamin D-Nanoemulsion (NVD): involvement of Wnt/β-catenin and other signal transduction pathways;发表期刊:Cell & Bioscience;影响因子:未明确提供;研究领域:结直肠癌分子治疗与信号通路调控。
结直肠癌是全球范围内高发的消化道恶性肿瘤,每年新发病例超百万,其发生发展与Wnt/β-catenin、PI3K/Akt等多条信号通路的异常激活密切相关。领域共识:Wnt/β-catenin通路的持续激活是结直肠癌发生的核心驱动因素之一,约80%的结直肠癌病例存在该通路的异常调控。维生素D及其类似物的抗肿瘤作用已被广泛报道,可通过抑制细胞增殖、诱导凋亡、调控信号通路等方式发挥作用,但天然维生素D存在生物利用度低、体内代谢快等局限性,限制了其临床应用。现有研究尚未系统探讨纳米剂型维生素D在结直肠癌中的作用及具体机制,因此本研究旨在制备维生素D纳米乳(NVD),并在细胞和动物模型中明确其对结直肠癌细胞的生长抑制效应及相关分子机制,为结直肠癌的新型治疗策略提供实验依据。需要注意的是,本研究论文已于后续被期刊撤回,其研究结论的可靠性需谨慎对待。
2. 文献综述解析
作者围绕维生素D的抗肿瘤作用及结直肠癌的信号通路调控展开综述,分类维度包括维生素D对不同信号通路的调控机制、现有剂型的局限性及纳米剂型的应用潜力。
现有研究显示,1,25(OH)₂D₃(活性维生素D)可通过结合维生素D受体(VDR)调控多条信号通路,包括抑制Wnt/β-catenin通路的激活、上调TGF-β受体表达、抑制EGFR信号传导等,从而在乳腺癌、前列腺癌、结直肠癌等多种肿瘤中发挥抗肿瘤作用;但天然维生素D的水溶性差、生物利用度低,限制了其临床转化,纳米剂型药物可有效提高药物的溶解度和生物利用度,已在多种肿瘤治疗中展现出优势,但针对维生素D纳米剂型在结直肠癌中的研究仍较为匮乏,缺乏系统的机制探讨。本研究的创新点在于首次制备了豌豆蛋白稳定的维生素D纳米乳(NVD),并通过细胞和动物实验系统解析其对结直肠癌细胞的生长抑制和凋亡诱导作用,重点聚焦Wnt/β-catenin通路的调控机制,弥补了现有研究在维生素D纳米剂型抗肿瘤机制方面的空白。
3. 研究思路总结与详细解析
本研究的核心目标是明确维生素D纳米乳(NVD)对结直肠癌细胞的抗肿瘤作用及相关分子机制,核心科学问题是NVD是否通过调控Wnt/β-catenin及其他信号通路抑制结直肠癌细胞增殖并诱导凋亡,技术路线为:制备并表征NVD→细胞实验验证NVD的生长抑制和凋亡诱导效应→分子实验解析相关信号通路机制→动物异种移植模型验证体内抗肿瘤作用。
3.1 维生素D纳米乳(NVD)的制备与表征
实验目的:制备具有高稳定性和生物活性的维生素D纳米乳,并对其理化性质进行表征。
方法细节:以豌豆蛋白为乳化剂,果胶为稳定剂,通过超声处理等方法制备NVD,检测其粒径、稳定性等指标,具体步骤为将豌豆蛋白溶解于去离子水,调节pH至12后进行超声处理,再调节pH至7,与维生素D混合后制备纳米乳,加入果胶作为稳定剂。
结果解读:制备的NVD具有良好的稳定性,粒径分布均匀,可有效提高维生素D的水溶性,为后续细胞和动物实验提供了基础。
产品关联:文献未提及具体实验产品,领域常规使用超声破碎仪、粒径分析仪等仪器,以及豌豆蛋白、果胶、维生素D原料等试剂。
3.2 细胞模型构建与药物处理
实验目的:构建结直肠癌细胞模型,确定NVD的有效处理浓度和时间。
方法细节:培养人结直肠癌细胞系HCT116和HT29,待细胞达到70%汇合度时,用不同浓度(10-100μM)的NVD和β-catenin抑制剂FH535处理24h或48h,DMSO作为对照,细胞培养于含10%胎牛血清和1%青霉素/链霉素的DMEM培养基中,置于37℃、5%CO₂培养箱中培养。
结果解读:细胞在70%汇合度时对药物处理的响应性较好,NVD处理呈现浓度和时间依赖性的效应,为后续实验确定了合适的处理条件。
产品关联:实验所用关键产品:DMEM培养基(ATCC®30–2002™)、胎牛血清(Gibco)、青霉素/链霉素、DMSO、FH535(β-catenin抑制剂)。
3.3 细胞活力与克隆形成能力检测
实验目的:验证NVD对结直肠癌细胞活力和克隆形成能力的抑制作用。
方法细节:采用MTT法检测细胞活力,将细胞接种于24孔板,每孔1×10⁴个细胞,处理48h后加入MTT试剂(5mg/ml PBS),孵育2h后加入DMSO,检测540nm处吸光度;克隆形成实验:将处理后的细胞接种于35mm培养皿,HCT116细胞每皿500个,HT29细胞每皿1000个,培养7天后用0.5%结晶紫染色,计数克隆数。
结果解读:NVD以浓度和时间依赖性方式抑制HCT116和HT29细胞的活力,HCT116细胞的IC₅₀在48h时为25.5μM,HT29细胞为30.3μM(n=3,P<0.001);NVD处理显著降低细胞的克隆形成能力,60μM NVD处理后HCT116细胞克隆数减少约60%(n=3,P<0.01)。

产品关联:实验所用关键产品:MTT试剂、结晶紫染色液、酶标仪(Elx 800)、菌落计数器(AO scientific)。
3.4 细胞周期与凋亡分析
实验目的:探讨NVD对结直肠癌细胞周期分布和凋亡的影响。
方法细节:细胞周期分析:用20-60μM NVD处理48h后,收集细胞,用1%多聚甲醛固定,再用70%乙醇固定过夜,用FITC和PI染色(Apo-Direct Kit,BD Pharmagen),通过流式细胞仪(FACScan,Becton–Dickinson)检测DNA含量,用ModiFitLT软件分析细胞周期分布;凋亡分析:用Annexin V-FITC和PI染色(Annexin-V-fluos staining Kit,Roche),流式细胞仪检测凋亡细胞比例。
结果解读:NVD处理使细胞周期阻滞在G2期,60μM NVD处理后HCT116细胞G2期比例从对照组的30.1%升至44.3%(n=3,P<0.001);NVD以浓度依赖性方式诱导细胞凋亡,60μM NVD处理后HCT116细胞凋亡率达54%(n=3,P<0.001)。

产品关联:实验所用关键产品:Apo-Direct Kit(BD Pharmagen)、Annexin-V-fluos staining Kit(Roche)、流式细胞仪(FACScan,Becton–Dickinson)、ModiFitLT软件。
3.5 分子机制检测(蛋白与基因表达分析)
实验目的:解析NVD调控结直肠癌细胞的分子通路机制。
方法细节:Western blot分析:收集处理后的细胞,用含蛋白酶和磷酸酶抑制剂的裂解液裂解,Bradford法测定蛋白浓度,取40μg蛋白进行SDS-PAGE电泳,转印至硝酸纤维素膜,用特异性抗体检测β-catenin、Akt、Survivin、细胞周期调控蛋白(Cyclin A、B1、E2、Cdc25c、P21)、凋亡相关蛋白(Bak、Bax、Bcl-xL、Caspase 3/7/9、PARP)等的表达,用Image J软件进行条带灰度分析;RT-PCR分析:用RNeasy Mini Kit提取总RNA,反转录为cDNA后进行实时荧光定量PCR,检测β-catenin等基因的表达;免疫荧光:细胞爬片处理后,用β-catenin抗体染色,DAPI复染细胞核,激光共聚焦显微镜观察细胞内定位。
结果解读:NVD处理显著下调β-catenin、Akt、Survivin的蛋白和基因表达,上调P21的表达,下调Cyclin A、B1、E2、Cdc25c的表达,同时上调促凋亡蛋白Bak、Bax的表达,下调抗凋亡蛋白Bcl-xL的表达,诱导Caspase 3/7/9和PARP的切割;免疫荧光显示NVD处理后β-catenin的核定位显著减少,表明其转录活性受到抑制。




产品关联:实验所用关键产品:蛋白酶和磷酸酶抑制剂鸡尾酒(Santa Cruz)、Bradford蛋白定量试剂盒、SDS-PAGE凝胶试剂、硝酸纤维素膜、化学发光试剂(Thermo Scientific)、Image J软件、RNeasy Mini Kit(Qiagen,Cat No.74104)、反转录试剂盒(BioLabs E6300)、SYBR Green Master(Roche)、免疫荧光抗体(未明确品牌)、DAPI(Invitrogen)、激光共聚焦显微镜(Zeiss 410)。
3.6 动物异种移植模型验证
实验目的:验证NVD在体内对结直肠癌的抗肿瘤作用。
方法细节:将HCT116细胞接种于裸鼠皮下,每只小鼠接种1×10⁶个细胞,与Matrigel按1:1混合,待肿瘤体积达可见大小后,将小鼠分为对照组(DMSO)、NVD处理组(15mg/kg、25mg/kg,腹腔注射,每周两次)、FH535处理组(15mg/kg、25mg/kg,腹腔注射,每周两次),每组6只小鼠,监测小鼠体重和肿瘤体积,实验结束后处死小鼠,取肿瘤组织进行Western blot、RT-PCR和免疫组化分析,取主要器官进行H&E染色检测毒性。
结果解读:NVD处理显著抑制肿瘤生长,25mg/kg NVD处理后肿瘤体积较对照组减少约60%(n=6,P<0.001),且未观察到明显的体重下降和器官毒性;肿瘤组织中β-catenin、Akt、Survivin的蛋白和基因表达显著下调,Caspase 3的切割增加,Cyclin D的表达下调,表明NVD在体内同样通过调控相关通路发挥抗肿瘤作用。




产品关联:实验所用关键产品:Matrigel(Collaborative Biomedical Products)、数字卡尺、免疫组化试剂(未明确品牌)、H&E染色试剂。
4. Biomarker研究及发现成果
本研究涉及的Biomarker包括Wnt/β-catenin通路关键分子β-catenin、PI3K/Akt通路分子Akt、抗凋亡蛋白Survivin,筛选逻辑基于这些分子在结直肠癌发生发展中的核心作用,通过“细胞实验筛选→分子机制验证→动物实验确认”的完整链条进行验证。
Biomarker定位
β-catenin作为结直肠癌的核心致癌Biomarker,其异常激活是结直肠癌发生的关键事件,约80%的结直肠癌病例存在β-catenin的异常积累或激活;Akt是PI3K/Akt通路的关键分子,参与细胞增殖、存活和代谢的调控,在结直肠癌中常呈异常激活状态;Survivin是IAP家族的抗凋亡蛋白,在结直肠癌中高表达,与肿瘤进展、不良预后和治疗耐药相关。本研究通过细胞和动物实验验证NVD对这些Biomarker的调控作用,明确其在NVD抗肿瘤效应中的核心地位。
研究过程详述
Biomarker的来源包括HCT116和HT29结直肠癌细胞系以及裸鼠异种移植瘤组织;验证方法包括Western blot(蛋白表达水平)、RT-PCR(基因转录水平)、免疫荧光(细胞内定位)、免疫组化(组织内表达分布);特异性与敏感性数据:NVD处理后,HCT116细胞中β-catenin的mRNA表达在60μM处理48h后降低约50%(n=3,P<0.01),蛋白表达降低约65%(n=3,P<0.001);Akt的磷酸化水平降低约70%(n=3,P<0.001);Survivin的蛋白表达降低约60%(n=3,P<0.01);动物实验中,25mg/kg NVD处理后肿瘤组织中β-catenin的mRNA表达降低约45%(n=6,P<0.01),Survivin蛋白表达降低约55%(n=6,P<0.01),且这些变化呈现浓度依赖性。
核心成果提炼
本研究发现NVD可通过下调β-catenin、Akt、Survivin等Biomarker的表达,抑制结直肠癌细胞的增殖并诱导凋亡,其中β-catenin的下调是核心机制,NVD通过抑制Wnt/β-catenin通路的激活,同时调控PI3K/Akt通路和凋亡相关蛋白的表达,发挥多通路协同的抗肿瘤作用;创新性在于首次系统验证了维生素D纳米乳对结直肠癌的抗肿瘤作用及相关通路机制,为结直肠癌的治疗提供了新的候选剂型和作用靶点;统计学结果显示所有差异均具有显著性(P<0.05或P<0.01或P<0.001),细胞实验样本量n=3,动物实验样本量n=6。需要注意的是,本研究论文已被期刊撤回,其研究结论的可靠性需谨慎评估,后续需更多独立研究进行验证。
